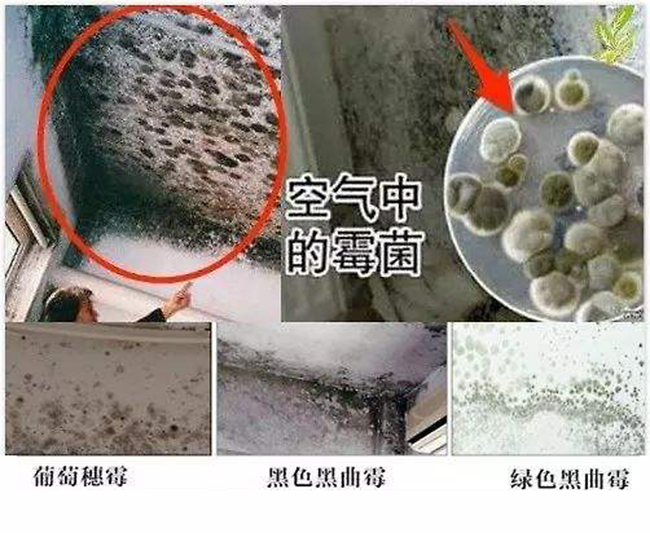
654645.jpg

康庭涂料:旧房翻新装修,除菌除霉解决方案!康庭漆 招商康庭涂料:旧房翻新装修,除菌除霉解决方案!
都知道南方天气总是阴雨连绵,下个雨半个月都不带停的。由于南方常年空气湿润,阴雨连绵。导致屋内阴暗潮湿,特别是旧房更为严重。这就给了大量霉菌肆虐繁殖的条件!可别小瞧这些霉菌,它的毒性大起来赶超砒霜,这些霉菌会释放一种孢子的化学物质。长期吸入会引起肺部感染导致呼吸道疾病严重时可致癌!!!
1、受天气潮湿或其它因素,会导致墙面到处都是霉菌,影响居家的美观。用水或其它洗涤液擦洗,过一段时间又会反复出现霉点,不能彻底清除。
2、想做全面的墙体翻新,成本又高,同时也给生活起居带来很多不方便。
3、长期待在有霉菌的环境,会引起身体不适,出现皮肤过敏、头痛、胸闷、鼻炎、咽喉炎等症状。康庭生态液专为室内墙面防菌除霉而开发的专用产品之一,有快速清除霉菌。长久抑制再生,以生物降解方式,将霉菌溶解成无害物质。
“真优美”除菌防霉生态液产品,采用高科技的新一代除霉配方,内含多种除霉因子,对霉菌进行迅速分解。纯水剂,除/防二合一,安全环保。10-30分钟快速见效,轻松解决墙面霉菌烦恼。康庭——专业翻新服务,为您提供"一站式翻新,全程无忧"的专业服务,专业翻新服务为您免去涂刷过程中的麻烦,做到省心放心安心。
推荐康庭翻新漆系列产品,让你翻新无烦恼,轻轻松松完成翻新装修。更多装修知识,请您继续关注康庭翻新漆,让您更省时、更省心、更省钱、轻轻松松搞定装修!
感谢关注康庭翻新漆!康庭,康庭漆,康庭涂料,康庭翻新漆,康庭网站,中山涂料,内外墙涂料,翻新涂料,涂料招商加盟,翻新漆,艺术涂料,真石漆,工程漆,木器漆,儿童漆,墙面漆、翻新水漆,涂料厂家、铜墙铁壁、彩色缤纷 选什么涂料好?